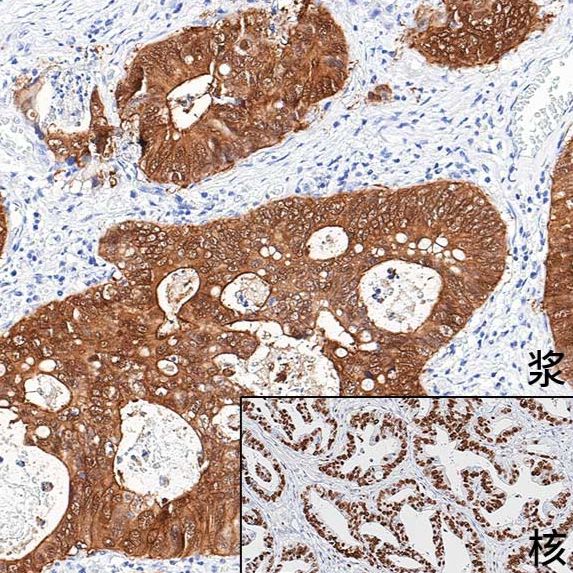
产品封面图

相关产品推荐更多 >
万千商家帮你免费找货
0 人在求购买到急需产品
- 详细信息
- 询价记录
- 文献和实验
- 技术资料
- 供应商:
北京云肽生物科技有限公司
- 库存:
99
我们北京云肽生物科技有限公司作为 中杉金桥 公司的特约经销商为客户提供,正规进口,保证原装正品,货期稳定,折扣好的服务标准。
北京中杉金桥生物技术有限公司建有专业的免疫组化实验室、分子病理实验室,2016年成为中国医学装备协会病理装备分会 shou jia 认证的免疫组化专项培训基地和分子病理培训基地。长期以来,公司积极参加病理行业协(学)会、认真落实行业政策,成为具有行业责任感和社会责任感的企业。公司获得中国医疗器械行业协会病理专业委员会、中国医学装备协会病理装备分会和北京肿瘤病理精准诊断研究会常务理事会员单位。
未来,我们将继续弘扬“立德、敬业”的企业精神,以高度的社会责任感和使命感,开拓创新、锐意进取。坚持以科学发展观为指导,以解决客户需求为目标,全心全意为用户提供 zui you 质的产品和服务。
中杉金桥 PV-6002 小鼠二步法试剂盒(小鼠聚合物法检测系统)110ml,产品简介:
产品品牌:中山金
产品货号:PV-6002
产品名称:小鼠二步法试剂盒(小鼠聚合物法检测系统)110ml
产品规格:110ml
中杉金桥 PV-6002 小鼠二步法试剂盒(小鼠聚合物法检测系统)110ml,产品说明:
分类: 检测系统
子分类: 非生物素法检测系统
主要成分:
试剂1:内源性过氧化物酶阻断剂
试剂2:酶标山羊抗小鼠IgG聚合物
检验方法: 1、检验所需仪器、设备:移液器、恒温箱、修复仪、免疫组化笔、计时器、孵育盒、染色架、盖玻片、光学显微镜、洗瓶。
2、试剂准备:DAB显色液需要在使用前配制。配制方法:在小试管中依次滴加底物缓冲液1mL,浓缩显色液(棕褐色液体)50µL,混匀。配置好的DAB显色液2~8℃避光存放,24小时内有效。
3、操作程序:
a) 脱蜡和水化
石蜡切片置于新鲜二甲苯中,浸泡10分钟×3次;去除多余的液体后,置于无水乙醇中,浸泡3分钟×3次;去除多余的液体后,置于95%乙醇中,浸泡3分钟×2次;去除多余的液体后,置于75%乙醇中,浸泡3分钟×2次;蒸馏水冲洗1分钟,置于PBS缓冲液中。
b) 抗原修复,参见一抗说明书。
c) 阻断内源性过氧化物酶
加入适量的内源性过氧化物酶阻断剂,室温孵育10分钟;PBS缓冲液冲洗3分钟×3次。
d) 滴加一抗
根据组织大小,滴加100μL或适量的一抗,37℃孵育60分钟;PBS缓冲液冲洗3分钟×3次。
e) 滴加酶标羊抗小鼠IgG聚合物
滴加100μL或适量的酶标羊抗小鼠IgG聚合物,37℃孵育20分钟;PBS缓冲液冲洗3分钟×3次。
f) 显色
加入适量新鲜配制的DAB或AEC显色液,室温孵育5~8分钟。
g) 复染
自来水冲洗,苏木素染色液孵育20秒;分化、冲洗返蓝。
h) 脱水、透明、封片
i) 阅片。
4、结果判定,染色结果须由有资质的病理医生对染色后的组织片在光学显微镜下观察并进行判读。
预期用途: 主要用于免疫组织化学染色的显色。
储存/效期: 2~8℃避光保存,不得冻存;产品有效期为12个月。
使用时即拿即放,单支试剂使用后应立即放回冰箱,开封后试剂有效期6个月。
产品订购信息:
PV-6002 中杉金桥 小鼠二步法试剂盒(小鼠聚合物法检测系统) 110ml
PV-6002 中杉金桥 小鼠二步法试剂盒(小鼠聚合物法检测系统) 55ml
PV-6002 中杉金桥 小鼠二步法试剂盒(小鼠聚合物法检测系统) 18ml
PV-6002 中杉金桥 小鼠二步法试剂盒(小鼠聚合物法检测系统) 6ml
PV-6002 中杉金桥 小鼠二步法试剂盒(小鼠聚合物法检测系统) 3ml
风险提示:丁香通仅作为第三方平台,为商家信息发布提供平台空间。用户咨询产品时请注意保护个人信息及财产安全,合理判断,谨慎选购商品,商家和用户对交易行为负责。对于医疗器械类产品,请先查证核实企业经营资质和医疗器械产品注册证情况。
- 作者
- 内容
- 询问日期
 文献和实验
文献和实验小鼠细小病毒(PV) 酶联免疫 分析( ELISA ) 试剂 盒使用说明书 本试剂仅供研究使用 目的:本试剂盒用于测定小鼠血清,血浆及相关液体样本中 细小病毒(PV)水平 。 实验原理 : 本试剂盒 采 用双抗 体 夹心 酶联免疫 法 (ELISA ) 测定 标本 中 小鼠 细小病毒(PV) 。用纯化的 小鼠 细小病毒(PV) 抗体 包被微孔板,制成固相 抗体 , 可与样品中 细小病毒(PV) 相结合 , 经洗
度提高了许多。 3)按结合方式可分为抗原-抗体结合,如过氧化物酶-抗过氧化物酶(PAP)法;亲和连接,如卵白素-生物素-过氧化物酶复合物(ABC)法、链霉菌抗生物素蛋白-过氧化物酶连结(SP)法等,其中 SP 法是比较常用的方法;聚合物链接,如即用型二步法,此方法尤其适合于内源性生物素含量高的组织抗原检测。 4. 目前几种常用免疫组化方法简单介绍 1)免疫荧光方法 是最早建立的免疫组织化学技术。它利用抗原抗体特异性结合的原理,先将已知抗体标上荧
应助后请跟贴,附上帖子链接,便于版主加分。 免疫组化讨论区 【求助】哪位大侠有TRAP试剂盒的使用说明啊 http://www.dxy.cn/bbs/post/view?bid=68&id=6728827&sty=1&tpg=9&age=0 【请教】非生物素的二步法试剂盒如何选择? http://www.dxy.cn/bbs/post/view?bid=68&id=6730777&sty=1&tpg=9&age=0 【求助】关于鱼血清纯化的详细步骤 http://www
 技术资料
技术资料暂无技术资料 索取技术资料